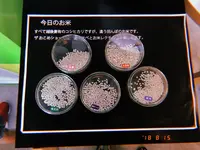

写真・動画(8件)
口コミ(1件)
ザおこめショー周辺のおでかけプラン
ザおこめショー周辺の人気スポット
-

越後妻有里山現代美術館キナーレ
ザおこめショーより約0m(徒歩1分)
OZmagazineTRIP 2022年秋号「秋の電車旅」に掲載されたスポット
-

道の駅 クロス10十日町
ザおこめショーより約110m(徒歩2分)
切符🎫
-

十日町駅
ザおこめショーより約530m(徒歩9分)
鉄印
-

越後妻有交流館キナーレ
ザおこめショーより約0m(徒歩1分)
アートトリエンナーレの拠点(?)。ここにも、いくつもの作品が展示されています。
-

小嶋屋
ザおこめショーより約490m(徒歩9分)
美味しいおそばとサクサクの天ぷら
-

いこて/IKOTE
ザおこめショーより約330m(徒歩6分)
OZmagazineTRIP 2022年秋号「秋の電車旅」に掲載されたスポット
-

道の駅 クロステン十日町
ザおこめショーより約70m(徒歩2分)
新潟の地酒やお土産が勢揃い。
-

タナカクマキチ
ザおこめショーより約410m(徒歩7分)
オススメは妻有ポーク。古民家を改装したおしゃれなカフェ。
-

小嶋屋和亭
ザおこめショーより約910m(徒歩16分)
-

Rolling Cylinder
ザおこめショーより約10m(徒歩1分)
「キナーレ」内。

「アートトリエンナーレ2018」。「キナーレ」内で会期中毎日、12:30〜、13:30〜、14:30〜開催。料金2,000円(お弁当、お味噌汁、おにぎり付き)。
2018年8月14日